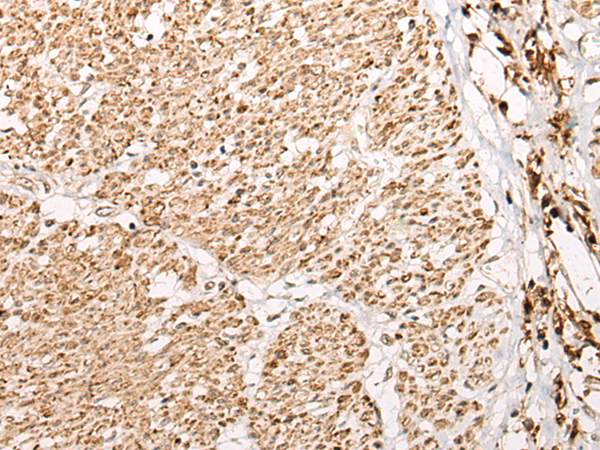

手機掃碼訪問本站

微信咨詢
|
Background: |
This gene encodes a phosphatidylinositol 3-phosphate-binding protein that functions as a master conductor for aggregate clearance by autophagy. This protein shuttles from the nuclear membrane to colocalize with aggregated proteins, where it complexes with other autophagic components to achieve macroautophagy-mediated clearance of these aggregated proteins. However, it is not necessary for starvation-induced macroautophagy. |
|
Applications: |
ELISA, IHC |
|
Name of antibody: |
WDFY3 |
|
Immunogen: |
Fusion protein of human WDFY3 |
|
Full name: |
WD repeat and FYVE domain containing 3 |
|
Synonyms: |
ALFY; ZFYVE25 |
|
SwissProt: |
Q8IZQ1 |
|
ELISA Recommended dilution: |
5000-10000 |
|
IHC positive control: |
Human thyroid cancer and human prostate cancer |
|
IHC Recommend dilution: |
25-100 |